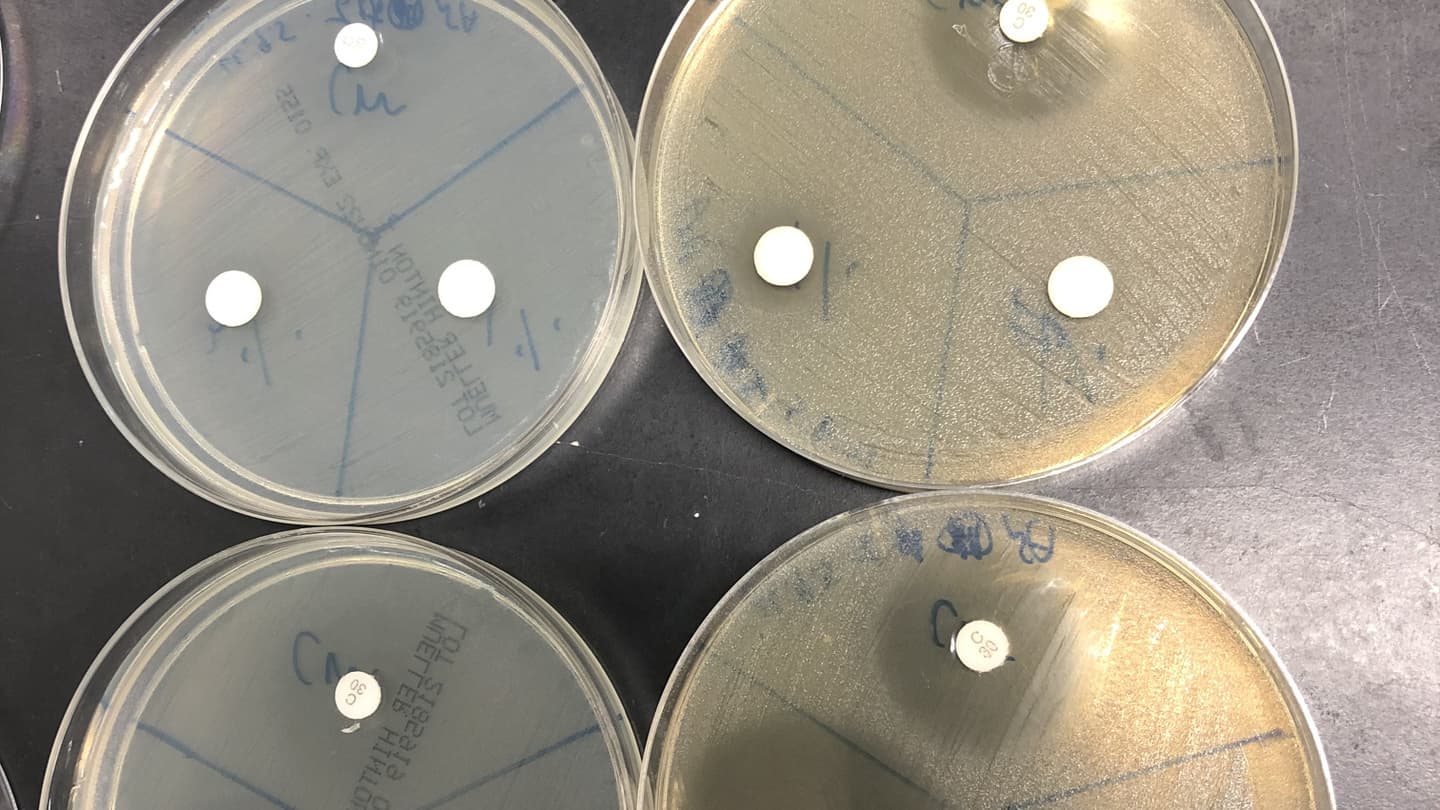

What's new ?
2025.9.1 | ラボ遠足(万博)に行ってきました。ミャクミャクにもユスリカにも会えました!写真はこちら |
---|---|
2025.6.24 | 九州大学、東北大学との共同研究チームで、世界初のATPプロドラッグが健康寿命延伸に寄与することを明らかにしました!論文はこちらプレスリリースはこちら |
2025.6.18 | 京都大学創立記念日に、生命科学研究科と医生物学研究所合同のソフトボール大会が行われました。お天気に恵まれましたが京都御所グラウンドは暑かった!写真はこちら |
2025.4.3 | 鴨川でお花見。ソフトボール大会に向けての練習も頑張りました!写真はこちら |
2025.3.26 | 生命科学研究科入試の現地説明会(4/5土)と医生物学研究所進学説明会(4/19土)が開催されます。ご興味のある方はぜひお越しください! |

線虫 C. elegans
体長約 1 mmと小さいながらも、基本的な組織・器官を備え、適用可能な分子遺伝学的ツールが豊富なことから、“ヒト”をはじめとする動物一般の生命の理を理解するためのモデル生物としてよく用いられています。
ラボの風景
主に腸内細菌を利用した老化や感染の制御を目指しています。
近年炎症は感染のみならず、さまざまな慢性疾患と密接に関わることが明らかになってきています。私たちは腸内細菌を利用した炎症抑制の可能性にも注目しています。
協力講座:大学院生命科学研究科 統合生命科学専攻 老化感染制御学分野から大学院生を受け入れます。
入試情報はこちらからご覧ください。
https://www.lif.kyoto-u.ac.jp/j/admission/